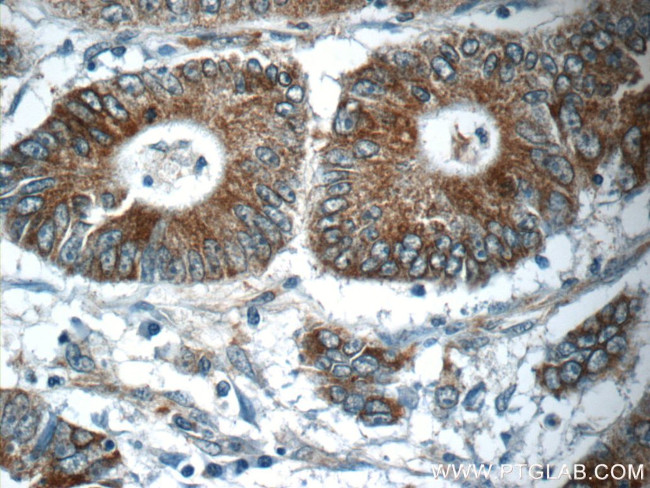
NPB Antibody in Immunohistochemistry (Paraffin) (IHC (P))

Search
Proteintech
NPB Polyclonal Antibody
{{$productOrderCtrl.translations['antibody.pdp.commerceCard.promotion.promotions']}}
{{$productOrderCtrl.translations['antibody.pdp.commerceCard.promotion.viewpromo']}}
{{$productOrderCtrl.translations['antibody.pdp.commerceCard.promotion.promocode']}}: {{promo.promoCode}} {{promo.promoTitle}} {{promo.promoDescription}}. {{$productOrderCtrl.translations['antibody.pdp.commerceCard.promotion.learnmore']}}
产品信息
25517-1-AP
种属反应
宿主/亚型
分类
类型
抗原
偶联物
形式
浓度
规格
纯化类型
保存液
内含物
保存条件
运输条件
产品详细信息
Immunogen sequence: ARRSQPYRG AEPPGGAGAS PELQLHPRLR SLAVCVQDVA PNLQRCERLP DGRGTYQCKA NVFLSLRAAD CLAA (53-125 aa encoded by BC126128)
靶标信息
Neuropeptide B is a endrogenous ligand of the orphan G protein coupled receptor GPR7. NPB and GPR7 exist in close proximity in the rat hypothalamus, and are ideally positioned to modulate neuroendocrine functions. NPB-immunoreactivity was enriched in many regions within the hypothalamus which also contained high levels of GPR7 mRNA including the ventrormedial hypothalamic nucleus, dorsomedial hypothalamic nucleus, arcuate nucleus, supraoptic retrochiasmatic nucleus, and in the area ventral to the zona incerta.
仅用于科研。不用于诊断过程。未经明确授权不得转售。
篇参考文献 (0)
生物信息学
蛋白别名: hPPL7; ligand of the GPR7 receptor; Neuropeptide B; prepro-NPB; preproneuropeptide B; Preproprotein L7
基因别名: L7; NPB; PPL7; PPNPB
UniProt ID: (Human) Q8NG41
Entrez Gene ID: (Human) 256933